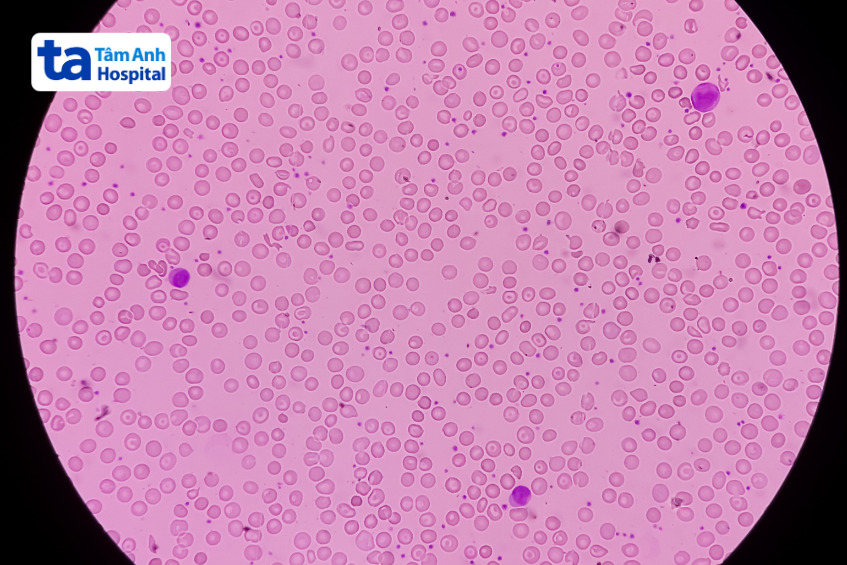
tế bào hồng cầu bị lỗi

Bệnh vỡ hồng cầu (hay tan máu) là hiện tượng các tế bào máu đỏ bị phá hủy, làm gián đoạn quá trình vận chuyển oxy trong cơ thể. Hồng cầu vỡ giải phóng vào máu có thể xảy ra do nhiều nguyên nhân khác nhau, cần được điều trị đúng cách và kịp thời.

Vỡ hồng cầu (hemolysis) hay còn gọi là tan máu, xảy ra khi tế bào hồng cầu bị phá hủy trước thời hạn thông thường, khiến hemoglobin và các thành phần nội bào giải phóng vào máu hoặc da, lách. Tùy theo vị trí xảy ra, tình trạng này được phân là hai loại chính: (1)
Tình trạng tế bào hồng cầu bị vỡ có thể gây nguy hiểm cho sức khỏe. Mức độ nguy hiểm của tình trạng này tùy thuộc vào các yếu tố như tốc độ phá hủy tế bào, khả năng sản sinh hồng cầu của tủy xương và nguyên nhân gây vỡ hồng cầu. Những rủi ro sức khỏe có thể xảy ra do hồng cầu bị vỡ không được xử trí kịp thời điển hình như:
Ngoài ra, tình trạng vỡ tế bào hồng cầu nghiêm trọng không được điều trị đúng cách và kịp thời có thể tiềm ẩn nguy cơ gây suy đa tạng đe dọa tính mạng của người bệnh. Tóm lại, hemolysis có thể gây hậu quả nghiêm trọng từ thiếu máu nhẹ đến tử vong nếu không điều trị kịp thời.

Như đã đề cập, tình trạng vỡ tế bào hồng cầu được phân thành hai nhóm chính là tan máu ngoại mạch và tan máu nội mạch. Việc phân loại này giúp xác định rõ cơ chế bệnh sinh cũng như hỗ trợ bác sĩ đưa ra phác đồ điều trị phù hợp.
Tan máu ngoại mạch là hiện tượng hồng cầu bị phá hủy chủ yếu tại các cơ quan thuộc hệ liên võng nội mô, đặc biệt là lách và gan. Tại đây, các đại thực bào đóng vai trò chính trong việc nhận diện và loại bỏ các hồng cầu bị biến dạng, già cỗi hoặc bị gắn kháng thể. Căn nguyên xảy ra tình trạng này là do cấu trúc bất thường hoặc thiếu hụt enzyme của tế bào hồng cầu khiến chúng dễ bị nhận diện là “lạ” và bị đại thực bào tiêu hủy.
Trong các trường hợp này, hồng cầu dễ bị biến dạng hoặc tổn thương trong quá trình lưu thông, dẫn đến bị giữ lại và phá hủy tại lách và gan. Các bệnh lý liên quan đến tình trạng tan máu ngoại mạch có thể kể đến như rối loạn màng tế bào hồng cầu như hereditary spherocytosis (bệnh cầu nhỏ di truyền), các bệnh lý do bất thường cấu trúc hemoglobin, hoặc thiếu hụt enzyme nội bào như thiếu G6PD (glucose-6-phosphate dehydrogenase)…
Tan máu nội mạch là quá trình phá hủy tế bào hồng cầu xảy ra trực tiếp trong lòng mạch máu, dẫn đến giải phóng hemoglobin tự do vào huyết tương. Đây là dạng tan máu nghiêm trọng vì hemoglobin tự do có thể gây độc cho thận và các mô khác nếu không được gắn kết và loại bỏ kịp thời. (2)
Tan máu nội mạch có thể xảy ra do nhiều nguyên nhân khác nhau, các yếu tố cơ học như van tim nhân tạo hoặc hệ thống tuần hoàn ngoài cơ thể (ECMO) cũng có thể gây vỡ hồng cầu do ma sát cơ học trong lòng mạch. Một số bệnh lý liên quan đến tình trạng tan máu nội mạch bao gồm:
Vỡ hồng cầu là hiện tượng hồng cầu bị phá hủy sớm trước thời hạn sống bình thường, có thể xảy ra trong lòng mạch hoặc tại các cơ quan như lách, gan. Nguyên nhân dẫn đến hiện tượng này rất đa dạng, bao gồm các bất thường bẩm sinh của hồng cầu, suy giảm hệ miễn dịch, nhiễm trùng, nhiễm độc, tác dụng phụ của thuốc, các rối loạn trong thai kỳ và yếu tố cơ học liên quan đến vận động hay can thiệp y khoa.
Một trong những nguyên nhân phổ biến của tan máu là sự bất thường của cấu trúc hoặc chức năng tế bào hồng cầu. Ở người bệnh thiếu men G6PD (glucose-6-phosphate dehydrogenase), tế bào hồng cầu không có khả năng chống lại stress oxy hóa, dẫn đến vỡ hồng cầu khi tiếp xúc với các yếu tố như thuốc gây oxy hóa (ví dụ: dapsone, sulfa…), nhiễm trùng…
Trong trường hợp mắc phải bệnh lý Hereditary Spherocytosis hoặc Elliptocytosis, màng hồng cầu bị biến dạng khiến tế bào mất đi tính linh hoạt, dễ bị giữ lại và phá hủy tại lách. Ngoài ra, các rối loạn hemoglobin như hồng cầu hình liềm hay thalassemia cũng khiến hồng cầu có hình dạng bất thường, dễ bị phá vỡ trong tuần hoàn (nội mạch) hoặc bị loại bỏ bởi hệ liên võng nội mô (ngoại mạch). (3)
Rối loạn miễn dịch cũng là một nguyên nhân quan trọng gây tan máu. Trong thiếu máu tan máu tự miễn (AIHA), cơ thể sinh ra kháng thể tấn công chính các hồng cầu của mình, dẫn đến hiện tượng gắn kháng thể lên bề mặt hồng cầu. Tùy theo loại kháng thể và cơ chế hoạt hóa bổ thể, tan máu có thể xảy ra ở ngoại mạch (do đại thực bào tiêu hủy) hoặc nội mạch (do bổ thể gây ly giải trực tiếp).
Bệnh tán huyết do bất đồng nhóm máu mẹ – con (HDN) xảy ra khi mẹ có kháng thể chống lại kháng nguyên hồng cầu của thai nhi (thường là Rh), dẫn đến tan máu nặng ở thai nhi hoặc sau sinh. Đây là tình trạng nghiêm trọng có thể đe dọa tính mạng của người bệnh cần phát hiện và can thiệp sớm để tránh biến chứng.
Ngoài ra, tình trạng vỡ hồng cầu cũng có thể xuất phát từ hội chứng thực bào máu – một rối loạn miễn dịch nghiêm trọng khiến các tế bào thực bào hoạt động quá mức, tiêu hủy hồng cầu và các tế bào máu khác.
Một số tác nhân nhiễm trùng có thể gây vỡ hồng cầu bằng nhiều cơ chế khác nhau. Ký sinh trùng sốt rét (Plasmodium spp.) và Babesia phá vỡ tế bào hồng cầu sau khi xâm nhập và sinh sản trong tế bào. Vi khuẩn Clostridium perfringens tiết ra độc tố có khả năng phá vỡ màng hồng cầu. Vi khuẩn Mycoplasma pneumoniae có thể kích thích phản ứng miễn dịch gây tan máu. Những trường hợp này thường kèm theo các triệu chứng toàn thân nặng và cần được điều trị bằng kháng sinh hoặc thuốc đặc hiệu.
Các chất độc gây stress oxy hóa mạnh có thể phá hủy màng hồng cầu hoặc gây tổn thương nội bào. Ví dụ, các hóa chất như dapsone, naphthalene (có trong long não) hay kim loại nặng như chì và đồng đều có khả năng gây tan máu, đặc biệt ở những người có sẵn yếu tố nguy cơ như thiếu G6PD. Tùy theo cơ chế tác động, tan máu có thể xảy ra ở cả nội mạch và ngoại mạch.
Nhiều loại thuốc có thể là nguyên nhân trực tiếp hoặc gián tiếp gây tan máu. Một số thuốc khi sử dụng dài hạn hoặc lạm dụng có thể gây phản ứng miễn dịch, kích thích cơ thể tạo ra kháng thể gắn lên hồng cầu và dẫn đến phá hủy tế bào hồng cầu. Ngoài ra, ở người bệnh thiếu men G6PD, việc sử dụng một số loại thuốc có thể gây stress oxy hóa, tiềm ẩn nguy cơ gây tổn thương và vỡ hồng cầu.
Một số rối loạn trong thai kỳ có thể khiến thai phụ bị tan máu nghiêm trọng. HELLP syndrome (tán huyết, tăng men gan, giảm tiểu cầu), TTP (ban xuất huyết giảm tiểu cầu huyết khối) và HUS thai kỳ (hội chứng tán huyết – urê huyết cao) là những vấn đề sức khỏe nghiêm trọng có liên quan đến tổn thương vi mạch nhỏ, gây tan máu nội mạch. Tan máu do biến chứng khi mang thai có thể gây tổn thương gan, thận và nguy cơ cao cho cả mẹ và thai nhi.

Hiện tượng vỡ tế bào hồng cầu cũng có thể xảy ra ở những người luyện tập thể thao cường độ cao, đặc biệt là các vận động viên chạy đường dài. Tình trạng này được gọi là “foot-strike hemolysis” hoặc “march hemoglobinuria”, bắt nguồn từ tình trạng va chạm cơ học liên tục giữa bàn chân và mặt đất khiến hồng cầu bị phá vỡ. Mặc dù không đe dọa tính mạng, tuy nhiên người bị vỡ hồng cầu do tập thể dục cường độ cao cần sớm đến bệnh viện để được thăm khám khi xấu hiện tình trạng thiếu máu hoặc nước tiểu sẫm màu.
Một số thiết bị y tế hỗ trợ tuần hoàn như ECMO (hệ thống oxy hóa màng ngoài cơ thể), CRRT (lọc máu liên tục) hay van tim cơ học có thể gây tổn thương cơ học lên tế bào hồng cầu trong quá trình lưu thông máu. Dòng máu đi qua các thiết bị này có thể tạo ra lực cắt mạnh hoặc dòng chảy xoáy, làm vỡ hồng cầu trong lòng mạch. Tan máu nội mạch kéo dài có thể gây thiếu máu, tăng bilirubin và tổn thương thận nếu không được theo dõi và xử lý kịp thời.
Dấu hiệu vỡ hồng cầu thường không rõ ràng, dễ bị nhầm lẫn với tình trạng sức khỏe thông thường khác. Vỡ tế bào hồng cầu có thể gây ra một số triệu chứng điển hình như:
Tình trạng vỡ tế bào hồng cầu không chỉ tiềm ẩn nhiều rủi ro sức khỏe, mà còn ảnh hưởng đến kết quả xét nghiệm máu, cụ thể:
Để chẩn đoán chính xác tình trạng vỡ tế bào hồng cầu, người bệnh cần trải qua quá trình thăm khám lâm sàng và thực hiện một số xét nghiệm theo chỉ định của bác sĩ, cụ thể:

Tùy thuộc vào nguyên nhân và mức độ nghiêm trọng, bác sĩ sẽ đưa ra phác đồ điều trị tình trạng vỡ tế bào hồng cầu, có thể bao gồm:
Để được thăm khám sâu hơn và theo dõi chuyên khoa huyết học tốt hơn, người bệnh có thể đến BVĐK Tâm Anh để được tư vấn và xây dựng phác đồ điều trị phù hợp.
Để dự phòng nguy cơ vỡ tế bào hồng cầu, mỗi người cần:
HỆ THỐNG BỆNH VIỆN ĐA KHOA TÂM ANH
Tóm lại, vỡ hồng cầu không chỉ là dấu hiệu cảnh báo những bất thường trong cơ thể mà còn là yếu tố góp phần thúc đẩy nhiều biến chứng nguy hiểm nếu không được phát hiện và xử lý kịp thời. Việc hiểu rõ nguyên nhân làm hồng cầu bị vỡ và các vấn đề liên quan sẽ giúp mỗi người nâng cao ý thức phòng ngừa và điều trị hiệu quả.